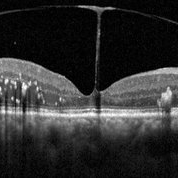

-
Vitreomacular traction
Vitreomacular traction
Jun 23 2022 by T. P . VIGNESH, MBBS,MS
SD-OCT of RE reveals Vitreomacular traction resembling bow and arrow and diabetic macular edema with intraretinal hard exudates in a 60 year old female patient with Moderate NPDR .
Imaging device: Heidelberg Spectralis
Condition/keywords: vitreomacular traction (VMT)

A project from the American Society of Retina Specialists